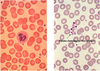

LEC 23: Heart I (Vessels, Blood, Microstructure)- Part II - 09.03.14 Flashcards
hematopoiesis
- formation and development of blood cells
- very few starting cells produce massive numbers of mature cells
- ~10 trillion blood cells are lost and replaced every day
Starting cells for hematopoiesis and their survival times
- red blood cells (4 months)
- leukocytes (10 hours)
- platelets (1 week)
NB: leukocytes = WBC (can be divided into granulocytes and agranulocytes)
Describe this slide of bone marrow

A. Red marrow
B. Yellow marrow
Bone marrow sample is usually taken from iliac crest, like coring an apple
Composition of blood
- cells
- red blood cells (RBC): carry oxygen
- leukocytes (WBC): fight infection
- thombocytes (platelets): hemostasis (control bleeding)
- plasma
- electrolytes: maintain tonicity
- proteins: albumin, globulins (antibodies), clotting factors
- lipids: serum
What percentage of blood is plasma? Cells?
- plasma (55%)
- cells (45%)
characteristics of blood cells
- short life span (except lymphocytes and macrophages)
- multiplicity of cell types
- widely distributed throughout the body
- bone marrow must respond quickly to emergency needs for additional cells
- stem cells must be maintained in adequate numbers through life (e.g. self-renewal)
What are the structures in this peripheral blood smear

A. Platelet
B. Red blood cell (RBC)
C. Neutrophil (WBC)
Erythroblasts vs. Erythrocytes
Erythroblasts = young/immature RBC found in bone marrow
- polychromatophilic erythroblasts = nucleated
- orthochromatic erythroblasts = as differentiate, nucleas gets smaller and is eventually extruded
Erythrocytes = mature RBC found in blood
- reticulocytes = immature RBC; count of reticulocytes used to check anemic patients

Size and shape of RBC
- nucleus of small mature lymphocytes are approximately same size as RBC
- biconcave disc (Surface Area important for gas exchange)
- structure important for deformability

Normal Red Cell Membrane
- lipid bilayer (slippery exterior impedes adherence to capillaries or aggregation)
- integral membrane proteins (chloride-bicarbonate exchange)
- cytoskeleton proteins (maintain cellular shape, deformability, tensile strength)

Characteristics of RBC
- anucleate
- lack organelles (cannot replenish enzymes or cytoskeletal proteins)
- anaerobic respiration
- 120 day life span
hemoglobin
- most abudant protein in blood
- transports oxygen from lungs to tissues
- transports CO2 from tissues to lungs
- Importance of Fe (Iron) molecule for binding
Types of RBC deformities
- elliptocytes (too flat)
- spherocytes (no concave disc)
- Sickle cells (inherited defect in structure)
- microcytes (RBC smaller than should be)

megakaryocytes
(mega- = large; karyo- = nucleus; cyte- = cell)
- can draw from bone marrow
- largest cell in bone marrow
- undergoes special division (only nucleus divies, not cell)
- multiple lobes
- cytoplasm breaks off, leaves marrow, becomes platelets
Characteristics of platelets
- anuclear
- 7-10 day life span
- all organelles
- electron dense granules
- contractile proteins (actin, myosin)
Platelet function
- first line of defense in hemostasis at site of vessel injury
- adhesion, activation, aggregation
- platform for fibrin formation (clot)
- mediate inflammation
- mediate vascular contriction (serotonin)
- mediate fibroblasts proliferation
thrombocytopenia
too few platelets
What are the 5 kinds of leukocytes (white blood cells)
GRANULOCYTES
- neutrophil
- eosinophil
- basophil
AGRANULOCYTES
- monocyte
- lymphocyte

Neutrophils
- polymorphonuclear leukocyte
- 6 hour lifespan in blood
- 1-5 day life span in tissue
- multilobed nucleus
- contractile proteins (actin, myosin)
- endocytosis/phagocytosis function
- 55-65% of WBC

Eosinophils
- biloped nucleus
- circulate for several hours after leaving marrow, then enter skin, pulmonary, or GI mucosa
- may migrate into local secretions
- phagocytize antigen-antibody complexes
- increased numbers in allergy and parasitic infections
- 2-5% of WBC

Basophils
- bilobed nucleus
- basophilic granules contain heparin and histamine
- mediate allergic responses
- precursors of tissue mast cells
- 1% of WBC

Monocytes
- eccentric, horeshoe-shaped nucleus
- phagocytize antibody or complement coated cells/organisms
- differentiate into tissue macrophages, living for months to years
- 3-8% of WBC

Lymphocytes

- effectors of immune response
- T cells: cell mediated immunity
- B cells: humoral immunity
- 20-25% of WBC
